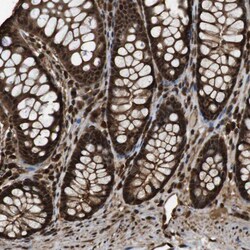
Invitrogen VCP Polyclonal Antibody 100 &mu;L | Buy Online | Invitrogen&trade; | Fisher Scientific

Learn More
Invitrogen™ VCP Polyclonal Antibody


Description
Immunogen sequence: PVAKDVDLEF LAKMTNGFSG ADLTEICQRA CKLAIRESIE SEIRRERERQ TNPSAMEVEE DDPVPEIRRD HFEEAMRFAR RSVSDNDIRK YEMFAQTLQQ SRGFGSFRF Highest antigen sequence indentity to the following orthologs: Rat - 100%, Mouse - 100%.

Specifications
Specifications
| Antigen | VCP |
| Applications | Immunohistochemistry (Paraffin), Western Blot, Immunocytochemistry |
| Classification | Polyclonal |
| Concentration | 0.1 mg/mL |
| Conjugate | Unconjugated |
| Formulation | PBS with 40% glycerol and 0.02% sodium azide; pH 7.2 |
| Gene | VCP |
| Gene Accession No. | P55072 |
| Gene Alias | 15S Mg(2+)-ATPase p97 subunit; 3110001E05; AAA ATPase p97; ALS14; CDC48; cell division cycle gene CDC48; CMT2Y; epididymis luminal protein 220; epididymis secretory protein Li 70; HEL-220; HEL-S-70; homolog of yeast cdc48; IBMPFD; IBMPFD1; Inv protein; or HEL-S-70; p97; p97 atpase; p97/VCP; Protein CDC48; si:ch211-113n10.2; TER ATPase; TERA; transitional endoplasmic reticulum ATPase; valosin containing protein; valosin-containing protein; Vcp; wu:fd16d05; wu:fj63d11; yeast Cdc48p homolog |
| Gene Symbols | VCP |
| Show More |
Safety and Handling
By clicking Submit, you acknowledge that you may be contacted by Fisher Scientific in regards to the feedback you have provided in this form. We will not share your information for any other purposes. All contact information provided shall also be maintained in accordance with our Privacy Policy.